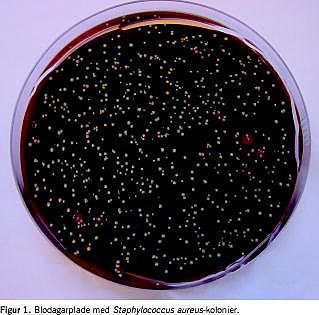

Introduktion: Staphylococcus aureus (Sa) er en vigtig årsag til hospitalsinfektioner, og Sa-bærertilstand er hyppig blandt sundhedspersonalet. Vi ønskede at undersøge, i hvilket omfang Sa-bærere spreder Sa og andre bakterier i luften, samt at undersøge om almindeligt anvendte værnemidler reducerede spredningen.
Materiale og metoder: I alt 13 Sa-bærere blev identificeret blandt 63 undersøgte. Spredningen af Sa og det totale antal bakterier, der overførtes fra disse bærere til luften, blev målt i forskellige situationer: ved almindelig vejrtrækning, bevægelse af armene, hvisken og høj tale. Alle fire situationer blev udført med og uden kittel, handsker, maske samt hue ud over det private tøj.
Resultater: Forsøget viste, at afgivelsen af Sa og det totale bakterieantal var størst, når forsøgspersonerne, der var iklædt privat tøj, bevægede armene. Spredning af Sa kunne reduceres til et minimum ved anvendelse af kittel, handsker og hue, fraset hos en enkelt forsøgsperson, hvor spredning først kom ned på niveau med kontrolværdien ved brug af maske i tillæg til ovenstående værnemidler. Hue, kittel og handsker medførte ligeledes en betydelig reduktion i spredningen af bakterier totalt, som dog først blev reduceret til et minimum, da forsøgspersonerne hertil yderligere bar en maske.
Konklusion: Vort forsøg underbygger rationalet for anvendelse af fuld iklædning - ikke alene på operationsgangen, men også eksempelvis ved anlæggelse af centralt venekateter.
Staphylococcus aureus (Sa) er en vigtig årsag til hospitalsinfektioner [1-4]. Ca. 25% af sundhedspersonalet er raske bærere af Sa. Bakterierne bæres i næsens forreste del og på huden, og de kan lejlighedsvis overføres til patienter og give anledning til infektioner [1-4].
Formålet med denne undersøgelse var at måle, i hvilket omfang nasale Sa-bærere spreder Sa og andre bakterier i luften, samt at undersøge om de almindeligt anvendte værnemidler, herunder hue, kittel, handsker og ansigtsmaske kan reducere spredningen.
Materiale og metoder
Undersøgelsen blev udført som led i gennemførelsen af et kandidatspeciale ved Syddansk Universitet. Medstuderende, kollegaer, venner og familie blev spurgt, om de ville deltage i en screening for, om de var nasale bærere af Sa. Screeningen blev udført med Klinisk Mikrobiologisk Afdelings rutinemetode med kulpodepind, Stuarts transportmedium og blodagarplade (Statens Serum Institut) [5]. Kulpodepindene drejedes rundt 2-3 gange ca. 1,5 cm inde i næsens forreste del [6]. Podepindene blev derefter opbevaret i Stuarts transportmedium i op til tre døgn, indtil de blev sået ud på blodagarplader. Disse blev inkuberet i et døgn ved 35 °C og derefter sat ud i dagslys i et døgn ved stuetemperatur. Sidstnævnte gøres for at få Sa til at danne pigment, hvorved de lettere identificeres. Alle kolonier, som var morfologisk forenelige med Sa, blev testet for koagulaseaktivitet ved hjælp af Staphaurex test (Remel). De fundne bærere blev ved forsøgets start atter podet ved ovenstående metode for at bekræfte deres bærerstatus. De personer, hos hvem den nasale Sa-bærestatus blev bekræftet ved anden podning, blev spurgt, om de ville deltage i forsøget. Der blev afgivet skriftligt og mundtligt samtykke.
Forsøget foregik i et rum med følgende dimensioner: bredde 5,65 m, længde 5,82, højde 3,60 = 119 m3 og almindelige ventilationsforhold (ca. 250 m3 /time). På et bord midt i rummet blev der placeret fire 14 cm-resistensplader (dansk blodagarplade, Statens Serum Institut) (Figur 1 ) [5]. Ved anvendelse af formel for beregning af areal for en cirkel, har hver resistensplade et areal på 154 cm2 , således at de fire resistensplader i alt har et samlet areal på 616 cm 2.
Resistenspladerne blev anbragt to og to, således at de tilsammen dannede et kvadrat på bordet 8,5 cm fra bordkanten, hvor forsøgspersonen skulle side. Der blev mærket af på bordet, så resistenspladerne havde samme placering hver gang. Forsøgspersonen blev anbragt på en stol tæt op ad bordkanten og sad foroverbøjet henover resistenspladerne.
Forud for forsøg med hver forsøgsperson blev luftens indhold af bakterier i det tomme rum målt som kontrol. Fire resistensplader blev anbragt på bordet i henhold til den ovenfor angivne beskrivelse og efterladt i rummet i 20 minutter.
Forsøgspersonerne skulle udføre forsøget enkeltvis. Hver forsøgsperson skulle gennemgå ni delforsøg.
Rækkefølgen af delforsøgene blev fastsat sådan, at de forsøg, hvor forsøgspersonen forventedes at afgive færrest bakterier, blev udført først, mens de forsøg, hvor forsøgspersonen forventedes at afgive flest bakterier, blev udført til sidst.
Forsøgspersonerne blev ved forsøgets start iklædt operationskittel (Tamro Medlab, standard op-gown reference 2200), hue, handsker samt maske, der dækkede næse og mund. Herunder havde de det samme private tøj på, som de havde haft på dagen før.
-
1. delforsøg skulle forsøgspersonerne sidde og trække vejret normalt med ansigtet ca. 15 cm over resistenspladerne.
-
2. delforsøg skulle personen sidde med armene ca. 15 cm over resistenspladerne og flektere og ekstendere i albueleddet i et forud defineret bevægemønster.
-
3. delforsøg skulle personen hviske med ansigtet ca. 15 cm over pladerne.
-
4. delforsøg skulle personen tale højt med ansigtet ca. 15 cm over pladerne.
Herefter fik forsøgspersonerne fjernet masken og skulle udføre delforsøg 5, 6, 7 og 8 som en gentagelse af delforsøg 1, 2, 3 og 4, men uden maske.
-
5. delforsøg skulle forsøgspersonerne sidde og trække vejret normalt igennem næsen med ansigtet ca. 15 cm over resistenspladerne.
-
6. delforsøg skulle personen sidde med armene ca. 15 cm over resistenspladerne og flektere og ekstendere i albueleddet i et forud defineret bevægemønster.
-
7. delforsøg skulle personen hviske med ansigtet ca. 15 cm over pladerne.
-
8. delforsøg skulle personen tale højt med ansigtet ca. 15 cm over pladerne.
Til sidst fik forsøgspersonerne fjer net kittel, hue og handsker, således at de kun havde deres private tøj på.
-
9. delforsøg skulle forsøgspersonen sidde med armene ca. 15 cm over resistenspladerne og flektere og ekstendere i albueleddet i et forud defineret bevægemønster.
I alle de delforsøg, hvori der ikke indgik bevægelse, havde forsøgspersonerne underarmene placeret på bordet. I hvert delforsøg blev der anbragt fire nye resistensplader, som skulle forblive på bordet i 15 minutter, hvoraf forsøgspersonen i de første ti minutter skulle sidde ved bordet og udføre delforsøget. Herefter forlod forsøgspersonen rummet, og pladerne blev efterladt åbne i yderligere fem minutter for at opsamle de resterende kim fra luften. Antallet af Sa, som kom ned på resistenspladerne, blev taget som mål for spredningen. Imellem hvert delforsøg blev bordet tørret af med hospitalssprit. De personer, som håndterede udskiftning af resistensplader samt aftørring af bordene med sprit, bar kittel og var ikke selv Sa-bærere.
Efter hvert forsøg blev resistenspladerne inkuberet i to døgn ved 35°C og derefter sat i dagslys ved stuetemperatur i to døgn. Pladerne blev herefter aflæst, idet det totale kolonital og antallet af Sa-kolonier blev talt hver for sig. Antallet af Sa blev bestemt ud fra kolonimorfologien samt koagulaseaktivitet.
Statistiske analyser blev foretaget med Wilcoxons matched-pairs signed-ranks test [7]. Signifikansgrænsen var 5%.
Resultater
I alt 63 raske voksne personer blev screenet for, om de var nasale bærere af Sa: 32 kvinder og 31 mænd i alderen 20 til 54 år. Blandt de 63 forsøgspersoner fandt vi ved første screening 16 Sa-bærere, hvilket svarer til 25%. Ved genpodning ca. en måned senere blev bærertilstanden bekræftet hos 14 af de oprindeligt 16 bærere: fire kvinder og ti mænd. I alt 22% af de screenede forsøgsdeltagere viste sig således at være permanente Sa-bærere. Tretten af de 14 bærere deltog i selve forsøget.
Forsøgsresultaterne fremgår af Tabel 1 . Afgivelsen af Sa og det totale bakterieantal var størst, når forsøgspersonerne var iklædt privat tøj og bevægede armene (delforsøg nr. 9). Der var dog stor spredning i afgivelsen af Sa fra person til person, idet stigningen i spredningen hos de enkelte forsøgspersoner spændte fra ingen stigning til en stigning med faktor 60 i forhold til kontrolværdien. En tilsvarende spredning sås i afgivelsen af det totale antal bakterier, således at de, som afgav flest Sa, også afgav det største antal bakterier totalt. To forsøgspersoner skilte sig ud ved at afgive særligt mange bakterier (forsøgsperson nr. 2 og 8).
Hue, hætte og overtrækskittel reducerede afgivelsen betragteligt (delforsøg 9 versus delforsøg 6. Sa: p ≤ 0,020. Totalt bakterieantal: p ≤ 0,0005). Forsøgsperson nr. 8 skilte sig dog stadig ud ved at afgive særligt mange bakterier (delforsøg 6). Da forsøgspersonerne endvidere blev iført mundbind, reduceredes den totale bakterieafgivelse yderligere (delforsøg 6 versus delforsøg 2, p ≤ 0,003), mens afgivelsen af Sa ikke reduceredes yderligere (p ≤ 0,6). I alle delforsøg, hvor der blev anvendt fuld iklædning (delforsøgene 1-4), nåede bakterieafgivelsen ned på et minimum, som ikke adskilte sig fra niveauet i kontrolopstillingen. Ansigtsmasker reducerede den totale afgivelse af bakterier, når man hviskede (delforsøg 3 versus delforsøg 7, p ≤ 0,0002), og når man talte højt (delforsøg 4 versus delsforsøg 8, p ≤ 0,0002), hvorimod der ikke var nogen signifikant effekt på afgivelsen af Sa.
Diskussion
Dette forsøg blev designet med henblik på at undersøge, i hvilket omfang nasal Sa-bærertilstand er forbundet med en spredning af Sa og andre bakterier ud i den omgivende luft, samt at undersøge om sædvanligt anvendte værnemidler (hue, kittel, handsker og maske) reducerer spredningen af bakterierne.
Tidligere studier har vist, at nasale Sa-bærere også har Sa på huden [8, 9]. Den største reduktion i spredningen af Sa til luften forekom som nævnt ved brug af hætte, handsker og kittel. Spredningen af Sa hos vores forsøgspersoner må således tænkes hovedsageligt at ske ved afgivelse fra tøj og hud. Ved friktion og bevægelse, frigives skæl, som indeholder bakterier og heriblandt Sa, til luften. Vores forsøg bekræfter således tidligere studier i at antallet af luftbårne bakterier, som afgives fra mund og næse, er insignifikant sammenlignet med det betydelige antal som afstødes fra tøj og hud [9-12].
Hos en enkelt forsøgsperson (forsøgsperson nr. 8) persisterede der dog en betydelig spredning af Sa på trods af, at hue, handsker og kittel havde reduceret spredningen betragteligt. Hos denne forsøgsperson blev afgivelsen af Sa først minimal, da forsøgspersonen i tillæg til hue, handsker og kittel ligeledes bar en maske. Forsøgsperson nr. 8 er en ung mand, som ikke adskiller sig fra de øvrige forsøgsdeltagere mht. helbred, hygiejne og livsstil.
Den direkte afgivelse af Sa fra næsen til den omgivende luft må derfor tænkes at udgøre en betydelig spredningsvej for forsøgsperson nr. 8's luftbårne spredning af Sa, hvorimod den ikke umiddelbart spiller nogen signifikant rolle ved de øvrige forsøgspersoners spredning af Sa. Masken kan således spille en rolle for reduktion af Sa-afgivelsen hos nogle Sa-personer [13]. I denne sammenhæng skal det dog fremhæves at, på trods af maskens betydelige rolle ved reduktion af den luftbårne spredning af Sa hos forsøgsperson nr. 8, skete langt den størst reduktion ved anvendelse af kittel, hue og handsker.
Hare & Thomas viste, at holdt man agarplader direkte under næsen på nasale Sa-bærere, var den luftbårne spredning af Sa ubetydelig ved nasal vejrtrækning, ved tale, hosten seks gange eller nys en enkelt gang [9]. Kun ved fnysen indtraf betydelig spredning. I modsætning hertil blev et stort antal Sa spredt ud i luften, da de samme forsøgspersoner bevægede sig. Vores forsøg understøtter dette.
Spredningen af både Sa og totale bakterier ud i luften viste stor variation mellem de enkelte forsøgsdeltagere. Forsøgspersonerne nr. 2 og 8 adskilte sig særligt fra de øvrige deltagere ved, at de spredte særligt mange Sa. Forsøgspersonerne nr. 1, 6 og 13 spredte derimod på trods af deres nasale Sa-bærertilstand ingen Sa i nogen af delforsøgene. Sa-bærertilstanden alene er således ikke tilstrækkelig at sprede Sa ud i luften. De fleste af forsøgspersonerne spredte få eller ingen SA til luften, mens forsøgspersonerne nr. 2 og nr. 8 i højere grad afgav Sa til den omgivende luft. Sidstnævnte to forsøgspersoner kan beskrives som spredere. Ca. 10% af raske Sa-bærere kan karakteriseres som spredere [4, 8, 14, 15], idet de i betydeligt omfang spreder Sa til luften.
En række studier har vist, at sprederne især afgiver Sa fra hud og tøj [9-11]. Karakteristisk for sprederne er, at de i højere grad har flere Sa på hud og hår end bærere, som ikke er spredere. White [8] og Ehrenkranz [16] viste, at luftbåren spredning af Sa er kvantitativt relateret til antallet af Sa-kolonier i næsen. Sa kan hyppigere isoleres fra huden af nasale bærere, der har kvantitativt store mængder af Sa i næsen end fra Sa-bærere, der har en lille mængde, hvilket er udtryk for, at hudens indhold af Sa skyldes en vedvarende tilførsel fra næsen. Bærere af en lille mængde Sa medfører ingen større spredning end personer, som ikke er nasale bærere. Tidligere studier har identificeret sprederne til hovedsageligt at være unge mænd [17, 18]. Både forsøgsperson nr. 2 og 8 var unge mænd på henholdsvis 26 og 27 år.
Forsøgsperson nr. 2 og 8, som afgav flest Sa ud i den omgivende luft, var ligeledes de forsø gspersoner, som spredte flest bakterier totalt.
Forsøgsresultaterne indikerer, at det almindeligt anvendte operationsudstyr i høj grad beskytter mod afgivelse af bakterier til luften. Selv hos sprederne, som i højere grad end andre spreder bakterier ud i den omgivende luft, vil brugen af hue, handsker, kittel og maske kunne reducere spredningen til et minimum. Ved brug af disse værnemidler vil sprederne således ikke udgøre en større smittekilde i operationsstuen end ikkespredere og ikkebærere, og de kan derfor uden begrænsninger agere heri.
Raad et al [19] fandt i deres studie at anvendelse af kittel, handsker, hue og maske og fuldafdækning ved anlæggelse af centralt venekateter reducerede antallet af kateterrelaterede infektioner. På den baggrund anbefales fuld iklædning med steril kittel, handsker, hue og maske ved anlæggelse af centralt venekateter [20]. Vores undersøgelse underbygger rationalet for denne anbefaling.
Aline Iskandar , Hestehøjvej 157, DK-5260 Odense S.
E-mail: aline_iskandar@yahoo.com
Antaget: 7. september 2008
Interessekonflikter: Ingen
<ol class="Litt-list">
<li>Belani A, Sherertz RJ, Sullivan ML et al. Outbreak of staphylcoccal infection in two hospital nurseries traced to a single nasal carrier. Infect Control 1986;7:487-90.</li>
<li>Hoeger PH, Elsner P. Staphylococcal scalded skin syndrome: transmission of exfoliatin-producing Staphylococcus aureus by an asymptomatic carrier. Pediatr Infect Dis J 1988;7:340-2.</li>
<li>Mulligan ME, Murray-Leisure KA, Ribner BS et al. Methicillin resistant Staphylococcus aureus: a consensus review of the microbiology, pathogenesis, and epidemiology with implications for prevention and management. Am J Med 1993;94:313-28.</li>
<li>Boyce JM, Opal SM, Potter-Bynoe G et al. Spread of methicillin-resistant Staphylococcus aureus in a hospital after exposure to a health care worker with chronic sinusitis. Clin Infect Dis 1993;17:496-504.</li>
<li>Substrathåndbogen, Statens Seruminstitut 1993, Skive: Bogtrykkeriet, Substratafdelingen, 1993.</li>
<li>www.ouh.dk/wm208810 (12. august 2008).</li>
<li>www.fon.hum.uva.nl/Service/Statistics.html (12. august 2008).</li>
<li>White A. Relation between quantitative nasal cultures and dissemination of staphylococci. J Lab Clin Med 1961;58:273-7.</li>
<li>Hare R, Thomas CG. The transmission of Staphylococcus aureus. BMJ 1956;2:840-4.</li>
<li>Mitchell NJ, Hunt S. Surgical face masks in modern operating rooms - a costly and unnecessary ritual? J Hosp Infect 1991;18:239-42.</li>
<li>Ritter MA, Eitzen H, French ML el al. The operating room environment as affected by people and the surgical face mask. Clin Orthop Relat Res 1975;111:147-50.</li>
<li>Noble WC, Davies RR. Studies on the dispersal of staphylococci. J Clin Pathol. 1965;18:16-9.</li>
<li>Sherertz RJ, Reagan DR, Hampton KD et al. A Cloud Adult: The Staphylococcus aureus - virus interaction revisited. Ann Intern Med 1996;124:539-47.</li>
<li>Huijsmans-Evers AG. Results of routine tests for the detection of dispersers of Staphylococcus aureus. Arch Chir Neerl 1978;30:141-50.</li>
<li>Noble WC. The dispersal of staphylococci in hospital wards. J Clin Pathol 1962;15:552-8.</li>
<li>Ehrenkranz NJ. Person-to-person transmission of staphylococcus aureus. N Engl J Med 1964;271:225-30.</li>
<li>Hill J, Howell A, Blowers R. Effect of clothing on dispersal of Staphylococcus aureus by males and females. Lancet 1974;2:1131-3.</li>
<li>Bethune DW, Blowers R, Parker M et al. Dispersal of Staphylococcus aureus by patients and surgical staff. Lancet 1965;1:480-3.</li>
<li>Raad II, Hohn DC, Gilbreath BJ et al. Prevention of central venous catheter-related infections by using maximal sterile barrier precautions during insertion. Infect Control Hosp Epidemiol 1994;15:231-8.</li>
<li>Dansk Standard: Styring af infektionshygiejne i sundhedssektoren - Del 3: Krav til brug af intravaskulære katetre. København: Dansk standard DS 2451-3, 2001.</li>
</ol>
Summary Dispersal of Staphylococcus Aureus from nasal carriers Ugeskr Læger 2009;171(6):420-423 Introduction: Staphylococcus aureus (Sa) is an important cause of hospital-acquired infections, and nasal carriage of Sa is common among health care workers. This study was designed to measure the airborne dispersal of Sa and other bacteria from such carriers and to investigate whether the use of cap, gown, gloves, and mask could reduce this dispersal.Material and methods: A total of 13 nasal Sa carriers were identified among 63 persons screened for Sa nasal carriage. The volunteers were studied for airborne dispersal of Sa in four different situations; quiet breathing, movements of the arms, whispering and loud talking. These activities were performed with and without gown, gloves, mask and cap upon street clothes. Results: The study showed that the highest number of Sa and bacteria in total was dispersed into the air when the volunteers were moving and wearing only their street clothes. The dispersal of Sa into the air was reduced into a minimum by wearing cap, gown and gloves, and no further significant decrease was achieved by wearing a mask. This applied for all volunteers except for one, who had to wear a mask in order to reduce his dispersal of Sa to a minimum. The total dispersal of bacteria was significantly reduced by wearing cap, gown and gloves; however, to reduce this dispersal to a minimum, volunteers also had to wear a mask. Conclusion: Our study supports the rational basis that gown, cap, gloves and mask should be used not only in the operating theatre, but also while e.g. inserting central venous catheters.